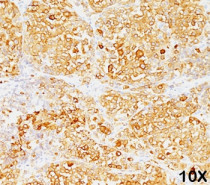

ARG55951
anti-MART1 / Melan A antibody [M2-9E3]
anti-MART1 / Melan A antibody [M2-9E3] for Flow cytometry,ICC/IF,IHC-Formalin-fixed paraffin-embedded sections,Western blot and Human,Mouse,Rat
Overview
| Product Description | Mouse Monoclonal antibody [M2-9E3] recognizes MART1 / Melan A |
|---|---|
| Tested Reactivity | Hu, Ms, Rat |
| Tested Application | FACS, ICC/IF, IHC-P, WB |
| Host | Mouse |
| Clonality | Monoclonal |
| Clone | M2-9E3 |
| Isotype | IgG2b, kappa |
| Target Name | MART1 / Melan A |
| Antigen Species | Human |
| Immunogen | Recombinant Human MART-1 protein. |
| Conjugation | Un-conjugated |
| Alternate Names | MART-1; MART1; Protein Melan-A; Antigen SK29-AA; Antigen LB39-AA; Melanoma antigen recognized by T-cells 1 |
Application Instructions
| Application Suggestion |
|
||||||||||
|---|---|---|---|---|---|---|---|---|---|---|---|
| Application Note | IHC-P: Antigen Retrieval: Boil tissue section in 10 mM Citrate buffer (pH 6.0) for 10-20 min, followed by cooling at RT for 20 min. * The dilutions indicate recommended starting dilutions and the optimal dilutions or concentrations should be determined by the scientist. |
Properties
| Form | Liquid |
|---|---|
| Purification | Purification with Protein G. |
| Buffer | PBS (pH 7.4), 0.05% Sodium azide and 0.1 mg/ml BSA |
| Preservative | 0.05% Sodium azide |
| Stabilizer | 0.1 mg/ml BSA |
| Concentration | 0.2 mg/ml |
| Storage Instruction | For continuous use, store undiluted antibody at 2-8°C for up to a week. For long-term storage, aliquot and store at -20°C or below. Storage in frost free freezers is not recommended. Avoid repeated freeze/thaw cycles. Suggest spin the vial prior to opening. The antibody solution should be gently mixed before use. |
| Note | For laboratory research only, not for drug, diagnostic or other use. |
Bioinformation
| Database Links |
Swiss-port # Q16655 Human Melanoma antigen recognized by T-cells 1 |
|---|---|
| Gene Symbol | MLANA |
| Gene Full Name | melan-A |
| Function | Involved in melanosome biogenesis by ensuring the stability of GPR143. Plays a vital role in the expression, stability, trafficking, and processing of melanocyte protein PMEL, which is critical to the formation of stage II melanosomes. [UniProt] |
| Cellular Localization | Cytoplasmic |
| Calculated MW | 13 kDa |
| PTM | Acylated. |
Images (2) Click the Picture to Zoom In
-
ARG55951 anti-MART1 / Melan A antibody [M2-9E3] IHC-P image
Immunohistochemistry: Formalin-fixed, paraffin-embedded Human melanoma stained with ARG55951 anti-MART1 / Melan A antibody [M2-9E3]. Note cytoplasmic cells.
-
ARG55951 anti-MART1 / Melan A antibody [M2-9E3] IHC-P image
Immunohistochemistry: Formalin-fixed, paraffin-embedded Human melanoma stained with ARG55951 anti-MART1 / Melan A antibody [M2-9E3]. Note cytoplasmic cells.